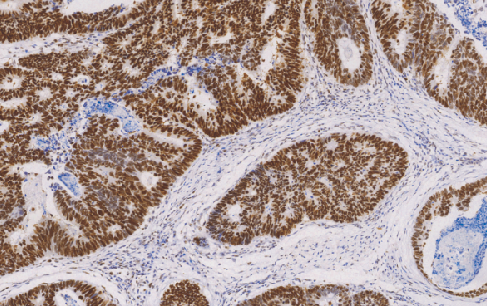
产品细节图片1
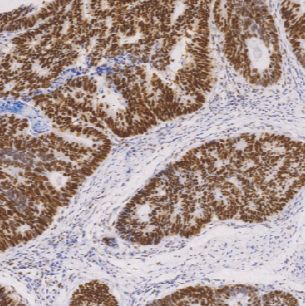
产品封面图

万千商家帮你免费找货
0 人在求购买到急需产品
- 详细信息
- 文献和实验
- 技术资料
- 形态:
Liquit
- 保存条件:
-20℃
- 克隆性:
单克隆
- 适应物种:
Human,(predicted:Mouse,Rat,)
- 保质期:
1年
- 抗原来源:
peptiede
- 目录编号:
TDCMM-0202
- 级别:
科研级
- 库存:
88
- 供应商:
武汉天德
- 宿主:
鼠
- 浓度:
1mg/ml
- 抗体英文名:
MismatCH Repair Protein(MSH6)
- 抗体名:
MismatCH Repair Protein(MSH6)
- 规格:
1ml工作液
Mismatch Repair Protein(MSH6)鼠抗人错配修复蛋白6单克隆抗体
MSH6全称为MutS homolog 6 (E.coli),是一种错配修复基因定位于2p16位上。通常微卫星重现性的改变是由于DNA复制时较链不对位产生滑动而导致微卫星不稳定 (即MSI)。微卫星不稳定,与常染色体的显性遗传性疾病相关,称为遗传性非息肉病性结、直肠癌,也可见于散发性结、直肠癌患者。MSH6常与MLH1、MSH2、PMS2联用,可用于患者对该疾病的筛查。
- 货号:TDCMM-0202
- 克隆号:C5D11
- 阳性部位:胞核
- 适用组织:石蜡切片
- 预处理:热修复
风险提示:丁香通仅作为第三方平台,为商家信息发布提供平台空间。用户咨询产品时请注意保护个人信息及财产安全,合理判断,谨慎选购商品,商家和用户对交易行为负责。对于医疗器械类产品,请先查证核实企业经营资质和医疗器械产品注册证情况。
文献和实验利用荧光显微镜可以对单个枯草杆菌细胞内DNA的修复组装和 DNA复制复合物进行成像,特别是可以成像错配修复蛋白,SOS诱导蛋白及同源重组、DNA复制状态。0:00 枯草杆菌DNA损伤的错配修复和细胞应激影像 0:21 内容订阅 0:45 内容简介 1:18 培养用于显微镜观察的细胞 4:55 准备用于成像的细胞 7:58 观察细胞 9:11 代表性枯草杆菌DNA损伤时的应激反应影像 10:05 结论 枯草杆菌DNA损伤的错配修复和细胞应激影像本视频来源于网络,如有异议请联系
抗体/补体介导的特异性细胞毒作用分离法分离T细胞亚群 人T淋巴细胞按其表面标志分为CD4+ T和CD8+ T细胞两类,其细胞膜上分别有CD4和CD8分子,当它们与相应的鼠抗人单克隆抗体结合后,在补体的参与下,可溶解相应的T细胞亚群,从而分离出另一种细胞亚群。 【试剂及配制】 (1) 聚蔗糖-泛影葡胺分层液(D=1.077±0.001)。 (2) Hank’s液(内含5%小牛血清和1.0g/L叠氮钠)。
R&D Systems 适用于神经细胞培养的无血清培养基添加剂
。 海马神经元表现出突触标记的可靠表达。e18大鼠海马神经元用添加了N21-MaX Media Supplement(目录号ar008)的培养基在体外培养21天。(a) 利用小鼠抗大鼠突触结合蛋白-1单克隆抗体(目录号MaB4364),以及Northernlights™ 557结合的驴抗小鼠igg二抗(目录号Nl007;黄色)对细胞染色,或(B) 利用小鼠抗人caM激酶iiα单克隆抗体(目录号MaB5584),接着用Northernlights™ 557结合的驴抗小鼠 igg二抗(目录号Nl
技术资料暂无技术资料 索取技术资料